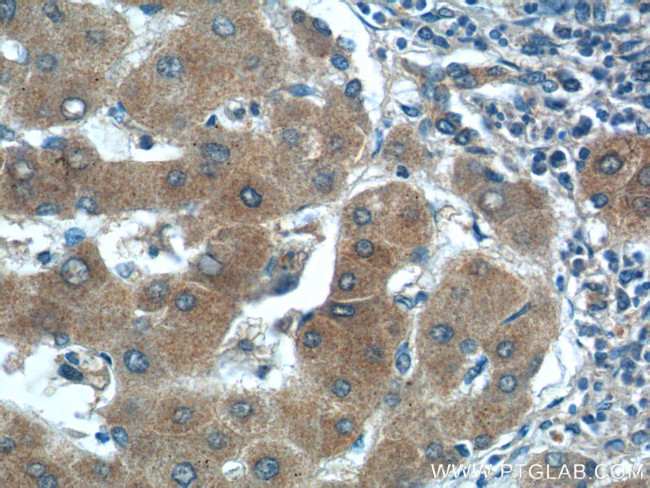
SMAD7 Antibody in Immunohistochemistry (Paraffin) (IHC (P))
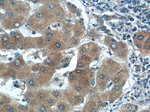
SMAD7 Antibody in Immunohistochemistry (Paraffin) (IHC (P))
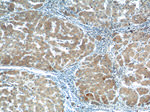
SMAD7 Antibody in Immunohistochemistry (Paraffin) (IHC (P))

Search
Proteintech
SMAD7 Polyclonal Antibody
{{$productOrderCtrl.translations['antibody.pdp.commerceCard.promotion.promotions']}}
{{$productOrderCtrl.translations['antibody.pdp.commerceCard.promotion.viewpromo']}}
{{$productOrderCtrl.translations['antibody.pdp.commerceCard.promotion.promocode']}}: {{promo.promoCode}} {{promo.promoTitle}} {{promo.promoDescription}}. {{$productOrderCtrl.translations['antibody.pdp.commerceCard.promotion.learnmore']}}
产品信息
25840-1-AP
种属反应
已发表种属
宿主/亚型
分类
类型
抗原
偶联物
形式
浓度
规格
纯化类型
保存液
内含物
保存条件
运输条件
产品详细信息
Immunogen sequence: MFRTKRSAL VRRLWRSRAP GGEDEEEGAG GGGGGGELRG EGATDSRAHG AGGGGPGRAG CCLGKAVRGA KGHHHPHPPA AGAGAAGGAE ADLKALTHSV LKKLKERQLE LLLQAVESRG GTRTACLLLP GRLDCRLGPG APAGAQPAQP PSSYSLPLLL CKVFRWPDLR HSSEVKRLCC CESYGKINPE LVCCNPHHLS RLCELESPPP PYSRYPMDFL KPTADCPDAV PSSAETGGTN YLAPGGLSDS QLLLEPGDRS HWCVVAYWEE KTRVGRLYCV QEPSLDIFYD LPQGNGFCLG QLNSDNKSQL VQKVRSKIGC GIQLTREVDG VWVYNRSSYP IFIKSATLDN PDSRTLLVHK VFPGFSIKAF DYEKAYSLQR PNDHEFMQQP WTGFTVQISF VKGWGQCYTR QFISSCPCWL EVIFNSR (1-426 aa encoded by BC074819)
靶标信息
SMADs are members of the MAD-related family of molecules. MAD-related proteins are a family of intracellular proteins that are essential components in the signaling pathways of the serine/threonine kinase receptors of the transforming growth factor beta superfamily. SMADs can be divided into receptor-regulated SMADs (R-SMADs: SMAD1, SMAD2, SMAD5, SMAD8 and SMAD9), common-mediator SMAD (co-SMAD: SMAD4), and inhibitory SMADs (I-SMADs: SMAD6 and SMAD7). SMAD1, SMAD5, SMAD8 and SMAD9 have high degrees of homology and antibodies are available that recognize sequences common to all of them. SMAD8 and SMAD9 are typically used as alternate names for one another in the literature.
仅用于科研。不用于诊断过程。未经明确授权不得转售。
生物信息学
蛋白别名: FLJ16482; hSMAD7; MAD (mothers against decapentaplegic, Drosophila) homolog 7; MAD homolog 7; MAD homolog 8; madh8; Mothers against decapentaplegic homolog 7; Mothers against decapentaplegic homolog 8; Mothers against decapentaplegic, drosophila, homolog of, 7; mothers against DPP homolog 7; mothers against DPP homolog 8; SMAD; SMAD 7; SMAD family member 7; SMAD, mothers against DPP homolog 7; unnamed protein product
基因别名: CRCS3; MADH7; MADH8; SMAD7
UniProt ID: (Human) O15105, (Mouse) O35253, (Rat) O88406
Entrez Gene ID: (Human) 4092, (Mouse) 17131, (Rat) 81516